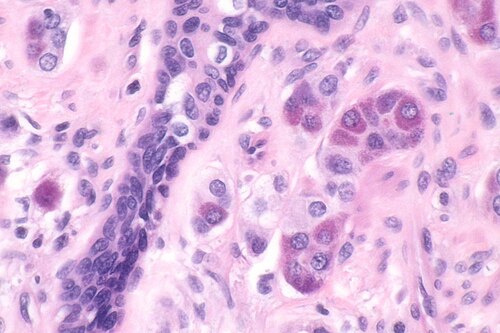

Paneth cell-like change of the prostate gland
(Redirected from PCLC)
Jump to navigation
Jump to search
Paneth cell-like change of the prostate gland. H&E stain. (WC/Nephron)
Paneth cell-like change of the prostate gland, abbreviated PCLC, is an uncommon histologic change in the prostate gland that may be seen in the context of benign or malignant glands.[1][2]
Microscopic
Features:
- Prostatic glands with a Paneth gland-like appearance:
- Eosinophilic cytoplastic granules.
Images
See also
References
- ↑ Weaver, MG.; Abdul-Karim, FW.; Srigley, J.; Bostwick, DG.; Ro, JY.; Ayala, AG. (Jan 1992). "Paneth cell-like change of the prostate gland. A histological, immunohistochemical, and electron microscopic study.". Am J Surg Pathol 16 (1): 62-8. PMID 1370193.
- ↑ Adlakha, H.; Bostwick, DG. (Feb 1994). "Paneth cell-like change in prostatic adenocarcinoma represents neuroendocrine differentiation: report of 30 cases.". Hum Pathol 25 (2): 135-9. PMID 7509774.


